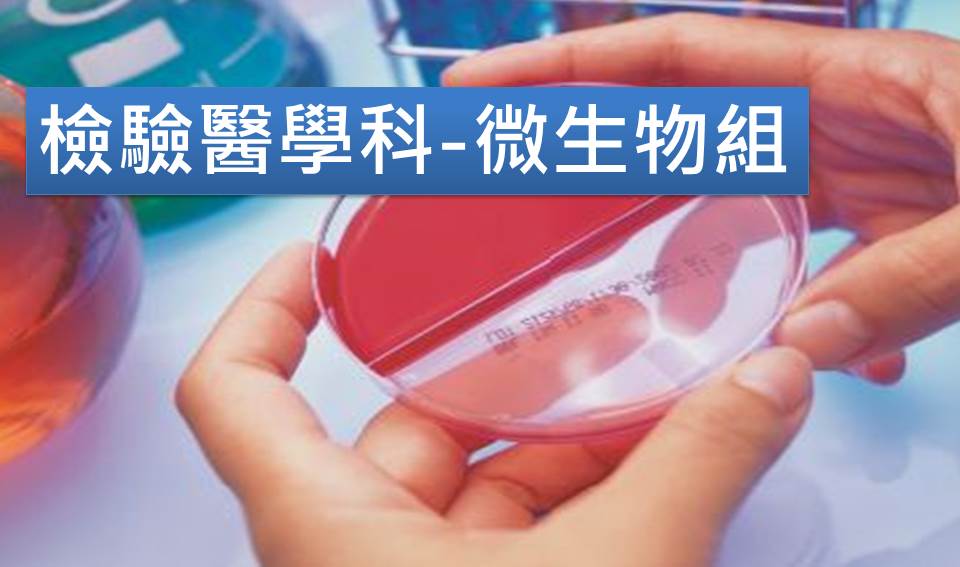

| 組別 | 姓名 | 職稱 | 分機 |
|---|---|---|---|
| 微生物組 | 林恩嫻 | 組長 | 5215 |
| 簡介 | ||
|---|---|---|
| 1. | 服務項目 | |
| 2. | 服務時間 | |
| 3. | 工作時效 | |
| 4. | 採檢配合事項 | |
| (一) 細菌培養。 | |
| (二) 黴菌培養。 | |
| (三) 分枝桿菌培養。 | |
| (四) 細菌染色檢查。 | |
| (五) 黴菌染色檢查。 | |
| (六) 分枝桿菌染色檢查。 |
| 常規收件操作時間: | |
|---|---|
| 星期一~星期五: | 上午08點至中午12點;下午01點30分至05點30分。 |
| 星期六: | 上午08點至下午04點。(依醫院公告門診時間) |
| ※ 常規收件時間外的檢體,請送到急檢暨生化組代收、接種。 | |
| 假日服務操作時間: | |
| ※ 星期六不操作TB培養檢驗;星期五送件的檢體,將延後於星期一下午發佈acid fast stain結果。 | |
| ※ 星期日及國定假日之上午08點至下午04點細菌室有專人值班。 | |